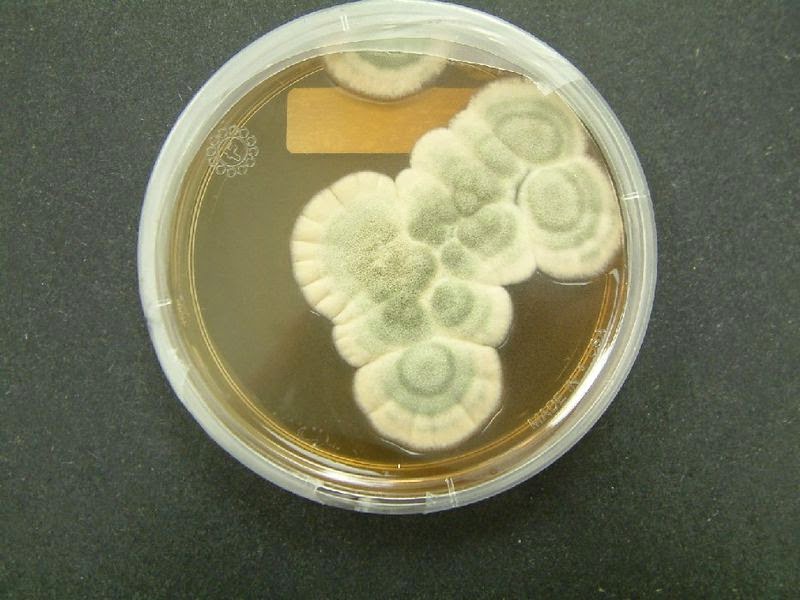

Por la cascada de tu cuerpo sangra mi memoria aromas de medianoche.
Sangra estelas de luz como arañas tejiendo cometas con la película epitelial con la que se enhebra la superficie de mi ceguera, detrás de la nebulosa del glaucoma.

La creciente se desborda, deriva de caricias, inerte, inefable, por la herida.
Una cascada de luz baja de tu sombra, se deslinda la noche de tus cabellos y una hondonada de ecos da a luz al escenario:
Una luciérnaga vive en tu vientre, una chicharra más abajo.
En el norte se constela tu nombre, mi mirada en el microscopio.
Por mi mirada el destello se avispa, se desenfoca su lente por los brotes de sus ramas sanguíneas. Por las orillas de la noche mana una grieta en mi memoria. Nadie le llama por su nombre a la ceniza.
Publicado originalmente como «Caja de Petri», en Asedio de la sombra (La Hoja Murmurante, Diciembre, 2007, Instituto Mexiquense de Cultura-La Tinta de Alcatraz